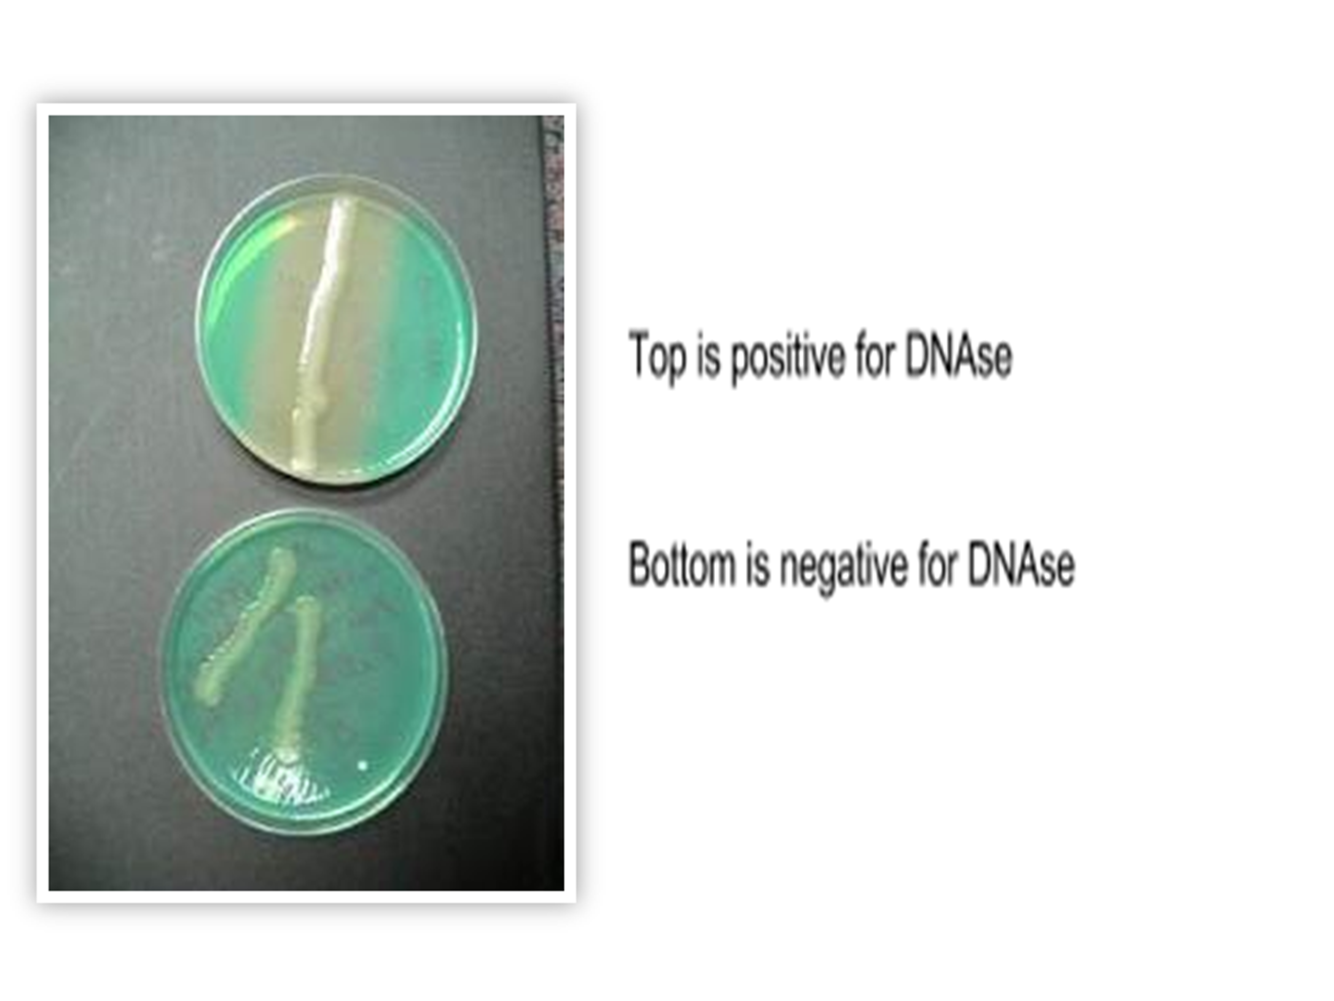

What is the Kirby-Bauer test used for?
to determine which antibiotics a specific bacterium is most susceptible or resistant to
What is meant by the term resistant?
Antibiotics will have no effect on bacteria growth; they don’t work
What is meant by the term susceptible?
Antibiotics work; bacteria is sensitive to antibiotics
What is a zone of inhibition?
Area of no growth
Why must a chart be used to read the results?
every antibiotic has different diameters in which they show they are effective
Given the information on a chart, be able to determine an antibiotics effectiveness
Disk potency: _____________________________
Resistant: _____________________________
Intermediate: _______________________
Susceptibility: __________________
PG. 34
1) measurement of antibiotic strength
2) the ability of the microbe to grow in the presence of antibiotics
3) bacteria falls short of resistance
4) antibiotics work
What is an antibiotic?
Substances that kill or prevent the growth of bacteria
What is the difference between broad spectrum and narrow spectrum? Why would one be used over the other?
Broad spectrum kills a large range of things while narrow spectrum targets a specific thing. We would use broad spectrum if we don’t know what is causing the disease. Narrow is when we have a good indicator as to what is causing disease
What is the difference between bacteriostatic and bactericidal?
Bacteriostatic: slows/stops bacteria growth
Bactericidal: kills bacteria
What is a disinfectant?
Chemical substances that kill or inhibit the growth of microorganisms.
How did we determine which disinfectant worked best?
seeing which disinfectant produced the largest zone of inhibition
What effect does pH have on bacterial growth?
What are the terms applied to bacteria at different pH ranges?
pH below 5.5 = _____________
pH 5.5 – 8.5 = _____________
pH above 8.5 = ____________
1) acidiophiles
2) neutrophiles
3) alkaliphiles
What effect does temperature have on bacterial growth?
What is meant by the term optimum temperature?
Optimum temperature: bacteria shows highest growth rate
What is meant by the term cardinal temperatures?
Cardinal temperatures: optimum, minimum, maximum temperatures
What are the terms applied to bacteria at different growth temperatures?
Grow <20˚C = _________________
Grow in freezing but can grow >30˚C = ____________
Grow in moderate temp. (15˚C – 45˚C) = ___________
Grow in warmer temp. (>40˚C) = ______________
Grow 65˚C – 110˚C = _________________
1) psychrophiles
2) psychrotrophs
3) mesophiles
4) thermophiles
5) extreme thermophiles
What is aerotolerance?
Refers to the ability of an organism to live & grow in the presence of oxygen
How can aerotolerance be tested?
What are the terms applied to each type of aerotolerance?
1= obligate aerobe, 2= obligate anaerobe 3= facultative anaerobes 5= aerotolerant

What test did we use to differentiate staphs from streps?
Catalase test

What are other ways that could have differentiated these two?
What specific tests/stains would help you differentiate?
1) By their morphology. Staphylococcus forms clusters of grape like shapes. While Streptococcus forms chains of “pearl necklaces.”
2) catalase, gram stain, simple stain,

What tests were used on the staphs?
to identify if a bacteria is _______________ by identifying the presence of the enzyme coagulase. Coagulase is an enzyme used by S. aureus to cause_________________________. WHICH acts as a mechanism of envading the hosts’ immune system.
1) Coagulase
2) staphlococcus aureus
3) the formation of blood plasma clots around themselves

What tests were used on the staphs?
1) DNAse
2) Staphylococcus aureus
3) Breaks down DNA
4) green